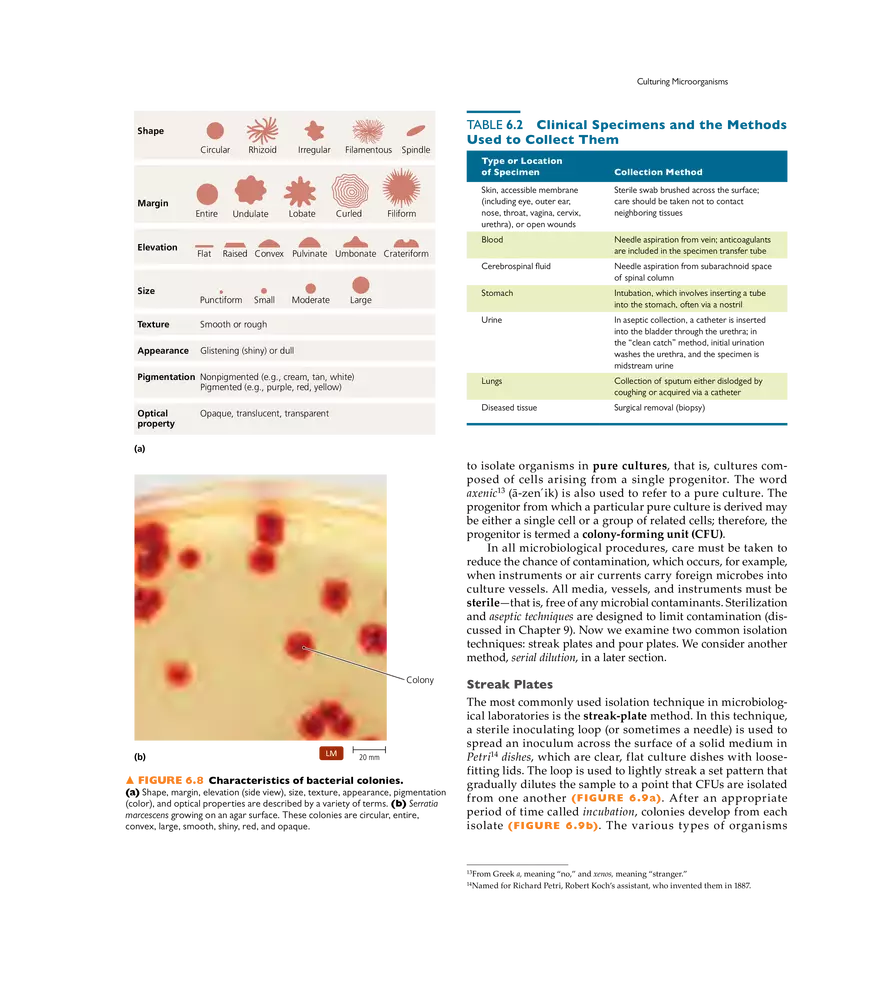
Microbial Nutrition and Growth - Page 3

Study Guide
Microbial Nutrition and Growth
-
University:
University of South Florida -
Course:
MCB 3020 | General Microbiology Academic year:
2022
-
Views:
412
Pages:
31
Author:
Hallie Randolph
Related Documents
- BI 212: Lecture 1 - Awnswer
- Connection System Circulation Blood with Health
- Tools of Blood Circulation
- Weekly Task 1 Assignment
- Biology Lab Summary 1
- Biology Lab Summary 2
- Biology Lab Summary 4
- Biology Quiz: Cell Cycle & DNA
- Blood Composition and Function
- Biology Lecture 2 - Answers
- Biology Lecture 1 - Answers
- BIO Lecture Notes
- Biology Lab Summary 6
- Biology Lab Summary 5
- Biology Lab Summary 3
- Strengthening Tissue - Lecture Notes
- Protective Tissue - Study Notes
- Basic Tissue - Biology Notes
- Circulation Systems on Animal
- Circulation Blood on Animal Vertebrates
Report
Tell us what’s wrong with it:
Thanks, got it!
We will moderate it soon!
Report
Tell us what’s wrong with it:
Free up your schedule!
Our EduBirdie Experts Are Here for You 24/7! Just fill out a form and let us know how we can assist you.
Take 5 seconds to unlock
Enter your email below and get instant access to your document